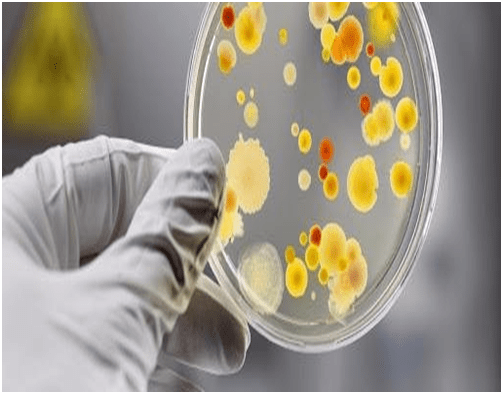

17:33
13.07.21
Археологи вновь раскопали Приморский бульвар в поисках археологических находок
Археологи под руководством доктора наук Светланы Ивановой начали новые раскопки на Приморском бульваре в центре Одессы и нашли несколько артефактов османского периода.
17:33
13.07.21
Археологи вновь раскопали Приморский бульвар в поисках археологических находок
Археологи под руководством доктора наук Светланы Ивановой начали новые раскопки на Приморском бульваре в центре Одессы и нашли несколько артефактов османского периода.